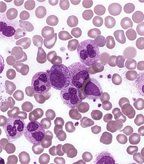

As CML Drugs Improve, Earlier Surrogate Outcome Markers Needed
As patients and physicians gain experience with a second generation of relatively effective therapies for chronic myeloid leukemia, there is increasing need to quickly understand who will fare best with these drugs.
As patients and physicians gain experience with a second generation of relatively effective therapies for chronic myeloid leukemia (CML), there is increasing need to quickly understand who will fare best with these drugs. It is possible that early surrogate markers, including complete cytogenetic response and major cytogenetic response at various time intervals, could effectively predict longer-term outcomes after treatment with BCR-ABL inhibitors, including nilotinib and dasatinib.
CML; source: Robert Cardiff, PhD
“Because of the relatively long natural history of CML-[chronic phase] and the high response rates achieved with available treatments, survival-based outcome measures require long-term evaluation,” wrote authors led by Frank Akwaa, MD, of the University of Rochester School of Medicine in New York. Dr Akwaa and Jane Liesveld, MD, also of the University of Rochester, evaluated short-term surrogate outcomes of chronic phase CML; the review was published online ahead of print in Leukemia & Lymphoma earlier this month.
There is now substantial evidence that 12-month response to the first-generation BCR-ABL inhibitor imatinib is a good indicator of long-term survival. The phase III IRIS trial showed that 97% of patients who achieved a complete cytogenetic response at 12 months had not progressed to advanced disease at 5 years, compared with 81% of those who had neither complete nor partial cytogenetic response at 12 months (P < .001). Even longer-term follow-up has confirmed this at 8 years.
With second-line therapies, including nilotinib and dasatinib, similar results have been shown, and even earlier surrogate outcomes could be used as well. One study showed that partial cytogenetic response with dasatinib at 6 months yielded a 50% chance of achieving a complete response at 2 years, compared with only 8% without such a response at 6 months. The same study later found that complete cytogenetic response at 6 and 12 months were correlated with 5-year progression-free survival rates of 83% and 79%, respectively; those without such a response at 6 and 12 months had progression-free survival rates of 31% and 35%, respectively.
A phase II trial of nilotinib also shows correlation between early response rates and longer-term outcomes. Among 321 patients, achievement of BCR-ABL1 levels of 10% or less by 3 months and 1% or less at 6 months was associated with better outcomes later in the trial.
“Based on higher [complete cytogenetic response] rates for both dasatinib and nilotinib compared with imatinib, it is likely that dasatinib and nilotinib treatment are associated with improved long-term outcomes,” the authors wrote, adding that longer follow-up from the second-generation drug phase III trials is needed to better understand the optimal surrogate endpoints. “Additionally, in light of the faster responses observed with dasatinib, nilotinib, and bosutinib compared with imatinib, new surrogate endpoints may need to be validated based on response at earlier time points than currently recommended for assessing optimal imatinib response.”